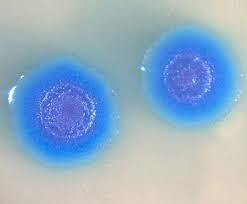
Creación de la primera célula viva sintética

-
 Aunque tuvieron algunas ideas equivocas con respecto al origen de la célula, lo importante de su existencia como científicos se centra en sus aportes.
Aunque tuvieron algunas ideas equivocas con respecto al origen de la célula, lo importante de su existencia como científicos se centra en sus aportes.
Schleiden sobre la teoría celular de animales y Schwann sobre la vegetal, determinaron que todos los organismos vivos están formados por células; que es la unidad funcional de vida. -
 Este proceso de división fue descubierto y explicado por Oscar Hertwig en 1876. Pero fue descrita nuevamente en 1883 por Edouard Van Beneden quien consolidaría el concepto como tal, al observar que la célula sufre dos divisiones sucesivas a diferencia de las asexuales. Entre 1890-1911 sin embargo, se descubrió la importancia para la reproducción y herencia genética en los seres vivos. Thomas Hunt Morgan con la observación del crossing-over en la meiosis, proporcionó una interpretación segura.
Este proceso de división fue descubierto y explicado por Oscar Hertwig en 1876. Pero fue descrita nuevamente en 1883 por Edouard Van Beneden quien consolidaría el concepto como tal, al observar que la célula sufre dos divisiones sucesivas a diferencia de las asexuales. Entre 1890-1911 sin embargo, se descubrió la importancia para la reproducción y herencia genética en los seres vivos. Thomas Hunt Morgan con la observación del crossing-over en la meiosis, proporcionó una interpretación segura. -
 Dos científicos independientes se dieron cuenta que los rayos X generan mutaciones en los genes, las cuales provocan cambios estructurales de las células, y por consecuencia, cambios fisiológicos en las personas que pudieran ser afectadas por estos.
Dos científicos independientes se dieron cuenta que los rayos X generan mutaciones en los genes, las cuales provocan cambios estructurales de las células, y por consecuencia, cambios fisiológicos en las personas que pudieran ser afectadas por estos. -
 En este año (1953) se hizo el descubrimiento de la estructura doble hélice de ADN. Por esto en 1962 recibieron el Premio Nobel de Medicina los físicos James Watson, Maurice Wilkins y Francis Crick. Estos concluyeron luego de varias interpretaciones que las cadenas de glucosa y fosfato se mantienen unidas de forma antiparalela por los puentes de hidrógeno en las bases nitrogenadas. Cada par de estas forman una especie de peldaño en esta "escalera caracol".
En este año (1953) se hizo el descubrimiento de la estructura doble hélice de ADN. Por esto en 1962 recibieron el Premio Nobel de Medicina los físicos James Watson, Maurice Wilkins y Francis Crick. Estos concluyeron luego de varias interpretaciones que las cadenas de glucosa y fosfato se mantienen unidas de forma antiparalela por los puentes de hidrógeno en las bases nitrogenadas. Cada par de estas forman una especie de peldaño en esta "escalera caracol". -
 Un conjunto de científicos destacan en este trabajo, pero quizá los más importantes sean: George Gamow, determinando la estructura de tripletes de 4 bases nitrogenadas; Marshall Warren Nirenberg, quien con otros dos científicos descifraron los codones de 54 aminoácidos; y quien completó el código fue Har Gobind Khorana.
Un conjunto de científicos destacan en este trabajo, pero quizá los más importantes sean: George Gamow, determinando la estructura de tripletes de 4 bases nitrogenadas; Marshall Warren Nirenberg, quien con otros dos científicos descifraron los codones de 54 aminoácidos; y quien completó el código fue Har Gobind Khorana. -
 Paul Zamecnik descubrió el ribosoma, organelo encargado de sintetizar proteínas dentro de las células. Junto con dos compañeros lograron detectar el elemento clave en comprender la síntesis de proteínas, el cual llamaron ARN. Este contiene información genética del ADN, la cual establece el orden de los aminoácidos en cadena que forman la proteína.
Paul Zamecnik descubrió el ribosoma, organelo encargado de sintetizar proteínas dentro de las células. Junto con dos compañeros lograron detectar el elemento clave en comprender la síntesis de proteínas, el cual llamaron ARN. Este contiene información genética del ADN, la cual establece el orden de los aminoácidos en cadena que forman la proteína. -
 Hizo tantos aportes que cuando recibió su Nobel preguntó: ¿por cuál de todas las cosas que hice me lo han dado? Entre sus aportes, los más importantes son: para el estudio de la ciencia y la comprensión de la genética y el comportamiento de las células el gusano C. Elegans, el ARN mensajero, la existencia de una traducción para el código genético del ADN.
Hizo tantos aportes que cuando recibió su Nobel preguntó: ¿por cuál de todas las cosas que hice me lo han dado? Entre sus aportes, los más importantes son: para el estudio de la ciencia y la comprensión de la genética y el comportamiento de las células el gusano C. Elegans, el ARN mensajero, la existencia de una traducción para el código genético del ADN. -
Los investigadores de este proyecto buscaban descifrar la secuencia de ADN de los cromosomas contenidos en el núcleo de cada célula humana (genoma).
Lograron determinar el orden y secuencia de todas nuestras bases de ADN; hicieron especies de mapas para mostrar la ubicación de los genes y mapas de enlace para poder estudiar los rasgos hereditarios a través de generaciones. Este proyecto duró 13 años y se completó en 2003. -
 Sus creadores fueron los científicos del Instituto Roslin de Edimburgo, Ian Wilmut y Keith Campbell. Una oveja de seis años fue el animal del que se extrajo la célula para su clonación. Coincidentemente Dolly, el primer mamífero clonado a partir de una célula vivió seis años, falleciendo de forma prematura.
Sus creadores fueron los científicos del Instituto Roslin de Edimburgo, Ian Wilmut y Keith Campbell. Una oveja de seis años fue el animal del que se extrajo la célula para su clonación. Coincidentemente Dolly, el primer mamífero clonado a partir de una célula vivió seis años, falleciendo de forma prematura.
Generó numerosos debates al descubrir los límites que ha alcanzado la ciencia y aún se cuestiona este método para los diferentes usos que puede llegar a tener. -
Es la primera forma de vida creada de manera artificial a partir de un genoma desarrollado en el laboratorio. No solo da un vuelco en lo que respecta a conocimiento biológico, si no al entendimiento de la vida y una mirada filosófica. Sus funciones en resumen son generar células vivas a partir de una mera secuencia genética guardada en un ordenador, y crear otros organismos con genomas más inventivos.
Es la primera forma de vida creada de manera artificial a partir de un genoma desarrollado en el laboratorio. No solo da un vuelco en lo que respecta a conocimiento biológico, si no al entendimiento de la vida y una mirada filosófica. Sus funciones en resumen son generar células vivas a partir de una mera secuencia genética guardada en un ordenador, y crear otros organismos con genomas más inventivos.
A list shows items. A timeline shows sequence.
Use Timetoast to make dates, milestones, and turning points easier to understand in a clear visual format. Timetoast is a timeline maker for work, school, research, and stories.
